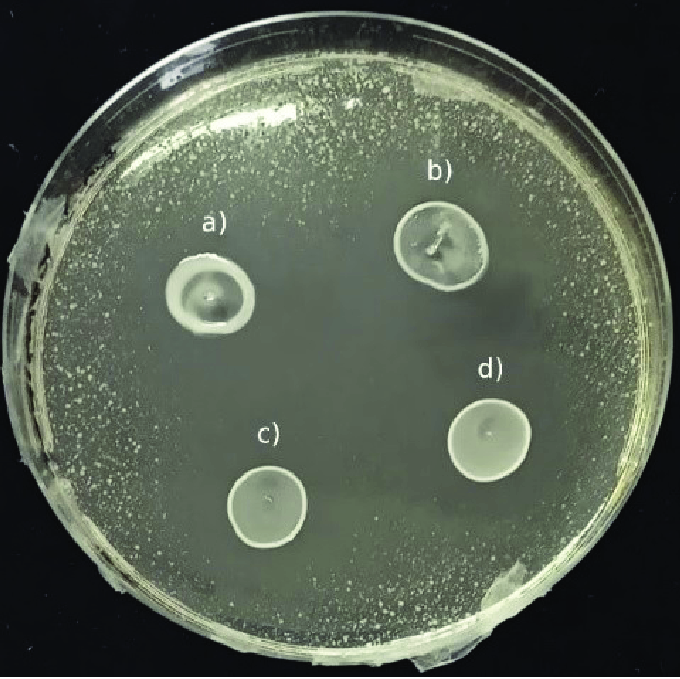

ผงแลคติไพลน์ติบาซิลลัส พลานตารัม คุณภาพสูง ยี่ห้อ IGC บริสุทธิ์ 100% ไทน์ดาลไลซ์ 100 พันล้าน CFU/กรัม สำหรับผลิตภัณฑ์ดูแลสุขภาพ
ยังไม่มีรีวิว

คุณลักษณะ
Maharashtra, Indiaสถานที่กำเนิด
30029030หมายเลขรุ่น
Powderชนิด
lactiplantibacillus plantarumProduct Name
White PowderAppearance
18 -24 MonthsShelf Life
Specification:Tyndallized
Storage:Cool Dry Place
Application:Health-care Products
Package:1kg/ Bag 25kg/drum
Potency:100Billion CFU/gram
คุณสมบัติที่สำคัญ
สถานที่กำเนิด
Maharashtra, India
หมายเลขรุ่น
30029030
ชนิด
Powder
Product Name
lactiplantibacillus plantarum
Appearance
White Powder
Shelf Life
18 -24 Months
Specification
Tyndallized
Storage
Cool Dry Place
Application
Health-care Products
Package
1kg/ Bag 25kg/drum
Potency
100Billion CFU/gram
บรรจุภัณฑ์และการนำส่ง
ขายหน่วย
รายการเดียว
เดี่ยวน้ำหนักรวม
12.000 กก.
ระยะเวลารอสินค้า
คำอธิบายผลิตภัณฑ์จากซัพพลายเออร์
1 - 9 กิโลกรัม
฿6,822.18
10 - 24 กิโลกรัม
฿6,028.91
25 - 49 กิโลกรัม
฿5,076.97
>= 50 กิโลกรัม
฿4,601.01
 ค่าธรรมเนียมในการนำเข้ารวมอยู่ใน (ตัวเลือกที่เลือก) แล้ว
ค่าธรรมเนียมในการนำเข้ารวมอยู่ใน (ตัวเลือกที่เลือก) แล้ว
ราคาตัวอย่างสินค้า :฿6,822.18
จำนวน
การจัดส่ง
ยอดรวมสินค้า
฿0.00
ค่าจัดส่งทั้งหมด
รอการต่อรอง
ยอดรวมย่อย
฿0.00
การคุ้มครองคำสั่งซื้อ Alibaba.com
การชำระเงินที่ปลอดภัย
ทุกการชำระเงินที่คุณทำบน Alibaba.com มีความปลอดภัยด้วยการเข้ารหัส SSL และโปรโตคอลการป้องกันข้อมูล PCI DSS ที่เข้มงวด
การคุ้มครองการคืนเงิน
รับเงินคืนหากคำสั่งซื้อไม่ถูกจัดส่ง สูญหาย หรือสินค้ามาถึงพร้อมกับปัญหาด้านคุณภาพ











